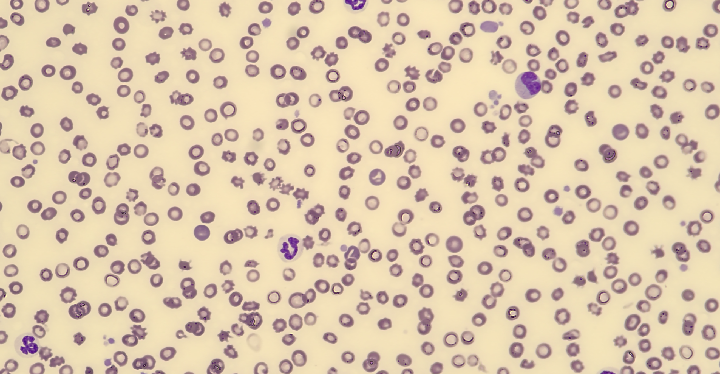
末梢血の塗抹

Immunology and Hematology
免疫・血液疾患外来
血液疾患
貧血
血液疾患の主な症状は「貧血」です。
日常診療では「貧血」で来院する犬猫が多く原因を調べるのは容易ではありません。
症状は食欲減退、活動量の低下、粘膜や皮膚の色の変化(白色、黄色)、血便や血尿、無症状など多岐にわたります。
「貧血」は病名ではなく症状ですから必ず原因があります。
その原因疾患を治療しないと貧血は改善しません。
そのためには身体検査(聴診、呼吸状態、可視粘膜の色、リンパ節の腫脹の有無、腫瘤性病変の有無、出血など)、画像検査、尿検査が必要です。
最も重要な検査が血液検査です。

血液検査
貧血の分類
骨髄検査
重度の貧血、非再生貧血、汎血球減少症(赤血球、白血球、血小板の3系列がすべて減少している)、血液塗抹に異型な細胞が観察される場合は骨髄検査が必要になります。

治療
原因疾患の治療が必要です。
白血病やリンパ腫さらに悪性腫瘍は抗がん剤を投与します。
免疫疾患ではステロイドホルモン、免疫抑制剤を使用します。
腎不全ではエリスロポエチン製剤、鉄剤の投与、重度の貧血では輸血を行います。
輸血は血液型が一致していることが原則で輸血動物に限りがあり何度も輸血することができないことがあります。
血液の腫瘍:リンパ腫
犬猫のリンパ腫は血液の腫瘍の中では最も多くみられます。
主に体表リンパ節、胃腸、肝臓、脾臓などに腫瘍性リンパ球が増殖浸潤していきます。
症状は体重減少、食欲不振、貧血、倦怠感、黄疸、下痢、嘔吐など多様な症状がみられます。
診断は腫瘍のみられる臓器の生検が重要で内視鏡、超音波エコーを使用して組織を採材(生検)して病理組織検査や特殊染色や遺伝子検査で確定診断をします。
犬は体表リンパ節が腫れるタイプ(多中心型)、腸に腫瘤ができるタイプ(消化器型)、
肝臓や脾臓がリンパ腫になるタイプが多いです。
猫は若い猫では胸部に腫瘤ができるタイプ(縦郭型)、中高年の猫では体重減少、慢性の下痢や嘔吐がみられるタイプ(消化器型)、腎臓が腫れるタイプ(腎臓型)がみられます。
治療は3~5種類の抗がん剤(多剤併用療法)とステロイドホルモンを主体とした薬剤を使用します。
リンパ腫は抗がん剤の効果が見られれば完全に消失(完全寛解)することを目標として、50%程度に縮小する場合(部分寛解)や効果が不十分な場合があります。
無治療では生存期間は短く1ヶ月程度と言われており、長生きするために抗がん剤治療を強く勧めています。


 TOPへ
TOPへ
 Web予約
Web予約


